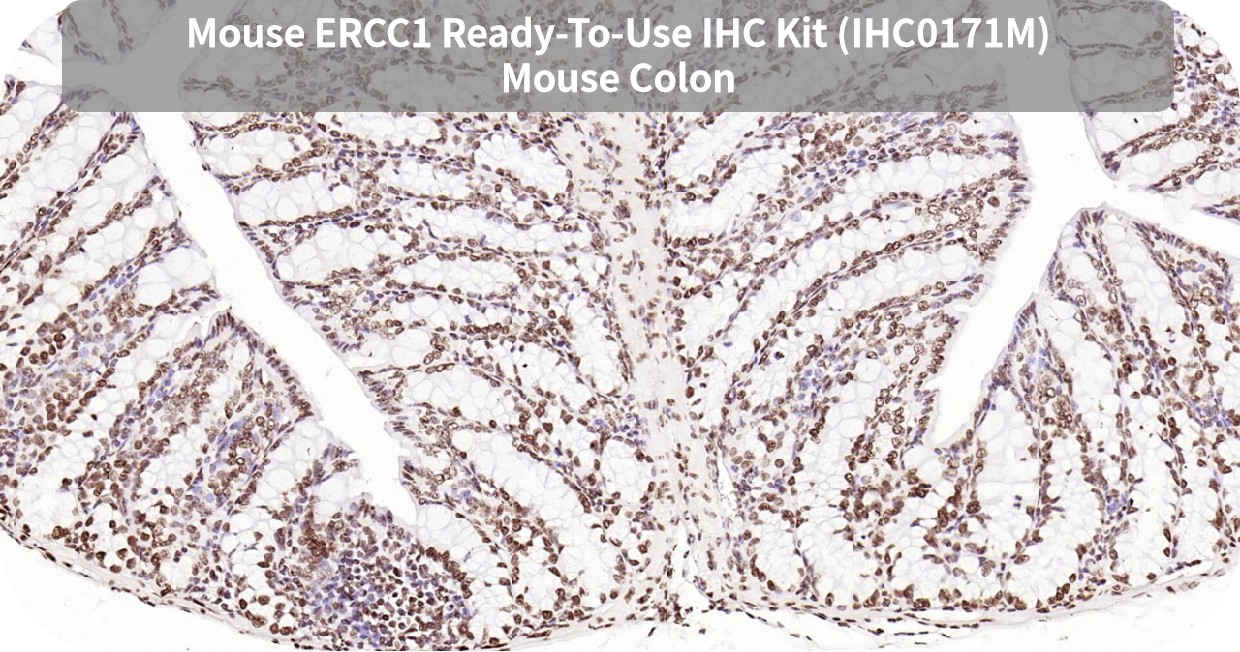
新闻图片6

10 年
手机商铺
公司新闻/正文
260 人阅读发布时间:2025-03-25 16:11

胰腺癌
胰腺癌(Pancreatic cancer)是起源于胰腺导管上皮及腺泡细胞的一种恶性肿瘤,恶性程度高、发展较快且预后较差。胰腺癌起病隐匿,早期几乎没有明显症状,等到出现腹痛、黄疸及消瘦等症状时,病程大多已进入中晚期。胰腺癌生存时间短,是预后最差的恶性肿瘤之一,从确诊到病情恶化往往只需数月时间,多数患者生存期不足一年。在全球癌症排行榜上,胰腺癌的发病率和死亡率都稳居前十名。胰腺癌的发病原因尚未十分明晰,但是已有研究表明,长期吸烟、不良的饮食习惯、肥胖和胰腺的慢性损害等因素都有可能会增加胰腺癌的风险。
分类
1.胰腺癌WHO组织学分型:
(1)起源于胰腺导管上皮的恶性肿瘤:导管腺癌、腺鳞癌和鳞癌、胶样癌、肝样腺癌、髓样癌、浸润性微乳头状癌、印戒细胞癌、未分化癌(间变型/肉瘤样型)、未分化癌伴破骨细胞样巨细胞、其他类型。
(2)起源于非胰腺导管上皮的恶性肿瘤:腺泡细胞癌、胰母细胞瘤、实性-假乳头状肿瘤、胰腺神经内分泌肿瘤。
2.按照发病部位分:
(1)胰头癌;
(2)胰体尾部癌。
症状
1. 腹部不适或腹痛:多数患者有腹痛并常为早期症状,位于中上腹深处,胰头癌略偏右,体尾癌则偏左。早期多数胰腺癌患者表现为上腹部不适或隐痛、钻痛、钝痛和胀痛等,逐步发展为持续性、进行性加重的中上腹疼痛,或者持续腰背部剧痛,餐后加剧。夜间和(或)仰卧与脊柱伸展时加剧,俯卧、蹲位、弯腰坐位或蜷膝侧卧位可使腹痛减轻。
2. 黄疸:黄疸是胰头癌最重要的临床表现,可与腹痛同时或在疼痛发生后不久出现。大多数病例的黄疸因胰头癌压迫或浸润胆总管引起,少数由于体尾癌转移至肝内或肝/胆总管淋巴结所致。黄疸表现为皮肤、巩膜变黄,小便深黄,大便呈陶土色,伴皮肤瘙痒,并进行性加重。
3. 消化道症状:最常见的症状是食欲不振和消化不良,与胆总管下端和胰腺导管被肿瘤阻塞,胆汁和胰液不能进入十二指肠有关。因胰腺外分泌功能不全,可致腹泻,脂肪泻多是晚期表现。部分患者常有恶心呕吐与腹胀。少数患者可因病变侵及胃、十二指肠壁而发生消化道梗阻或出血,多数患者有持续或间歇性低热。
4. 消瘦和乏力:起病之初即可出现明显的消瘦,体重下降,晚期出现恶病质,患者极度消瘦,贫血、无力,甚至完全卧床,生活不能自理,极度痛苦,全身衰竭。
5. 糖尿病相关症状:可出现胰源性糖尿病或原有糖尿病加重。
6. 精神或情绪障碍表现:部分病人出现抑郁、焦虑、狂躁等精神或情绪障碍表现。
病因
1. 癌前病变:癌前病变是组织的病理性状态,并非是癌,但在其基础上可能会增加组织癌变的几率,进一步发展癌变。胰腺导管上皮的不典型增生是胰腺癌的癌前病变,胰腺导管内乳头状黏液瘤亦是一种癌前病变。
2. 基因异常:近年来,关于胰腺癌基因突变的研究很多,已经发现携带BRCA1、BRCA2、CDKN2A、TP53、MLH1和ATM等基因突变的个体患胰腺癌风险显著上升。CDKN2A、BRCA1/2、PALB2等基因突变被证实与家族性胰腺癌发病密切相关。分子生物学研究提示,癌基因激活与抑癌基因失活以及DNA修复基因异常在胰腺癌的发生中起着重要作用,如90%的胰腺癌可有K-ras基因第12号密码子的点突变。
3. 遗传因素:一级亲属有胰腺癌病史者,其患胰腺癌的概率会大大增加。此外,多种消化系统的遗传性疾病都与胰腺癌关系密切,比如Peutz-Jeghers综合征(家族性黏膜皮肤色素沉着胃肠道息肉病)、Lynch综合征(遗传性非息肉病性结直肠癌)、家族性腺瘤息肉病等。
诱发因素
1. 长期吸烟:长期吸烟是公认的致癌原因,吸烟数量与胰腺癌死亡率成正相关。
2. 不良的饮食习惯:如长期饮酒、高脂肪和高蛋白饮食、长期大量饮用咖啡等,可以刺激胰腺分泌,诱发胰腺炎,增加胰腺癌发生风险。
3. 肥胖:尤其是体质指数(BMI)≥35kg/m2时,胰腺癌患病风险增加50%。
4. 胰腺的慢性损害:慢性胰腺炎,特别是对于家族性胰腺癌患者,可能成为胰腺癌的诱因。病史超过10年的糖尿病患者,罹患胰腺癌的风险也明显增加。新近发生糖尿病、年龄>50岁、没有糖尿病家族史者,发生胰腺癌的危险性增加。
5. 化学物质:长期接触某些化学物质,如F-萘酸胺、烃化物等,可能对胰腺有致癌作用。
6. 内分泌:男性发病率较绝经期前的女性为高,女性在绝经期后则发病率上升。
胰腺癌常用肿瘤标志物
1. S100 Calcium Binding Protein P(S100P)
S100P是S100家族成员之一,除了胎盘,S100P还表达于许多其他类型的正常组织,包括心肌和骨骼肌、胃肠道和前列腺的上皮细胞以及肾脏、膀胱和白细胞。S100P在多种肿瘤中表达,如非小细胞肺癌、乳腺癌、胰腺癌(包括胰腺导管腺癌、胰腺导管内乳头状黏液性肿瘤和癌前细胞)、胃腺癌和结直肠腺癌、移行细胞癌、卵巢癌和黑色素瘤等。
胰腺的正常及炎症组织中缺乏S100P表达,因此S100P的广泛表达是诊断胰腺癌的有用标志物,特别是在小活检和细针穿刺样本中,并且S100P的表达通常与不良预后相关。S100P在胰腺内分泌肿瘤和腺泡细胞癌中呈阴性。
2. MUC1
MUC1是一种I型单次跨膜蛋白,位于上皮细胞的管腔表面,通过粘膜表面形成保护性屏障,有助于维持黏膜屏障的完整性,保护细胞免受极端环境条件的影响。MUC1可以在正常细胞中充当润滑剂、保湿剂和物理屏障。通常在乳腺、食道、胃、十二指肠、胰腺、子宫、前列腺和肺的腺或管腔上皮细胞中表达,在造血细胞中少量表达,在皮肤上皮和间充质细胞中不表达。MUC1在上皮来源的肿瘤中可以高度表达,包括肺癌、前列腺癌、乳腺癌、膀胱癌、胰腺癌和卵巢癌,并与预后不良有关。
MUC1参与细胞内信号传导过程和相关生物分子的调节,在正常细胞中,MUC1以高度糖基化形式存在。而在肿瘤细胞中,MUC1表达上调,并经历异常的糖基化和过表达。上调的MUC1参与了多种信号通路的调节,并在肿瘤细胞的生长、代谢、增殖、凋亡、上皮间质转化、侵袭和转移中发挥重要作用。
3. 间皮素(MSLN)
MSLN(Mesothelin)是一种糖基磷脂酰肌醇(GPI)锚定的细胞表面糖蛋白,属于分化抗原簇(CD)家族成员之一,表达于正常的间皮细胞上,因此命名为间皮素。MSLN在正常组织中表达有限,主要表达于胸膜、腹膜和心包的正常间皮细胞。但在多种恶性肿瘤中,如间皮瘤、胰腺癌、卵巢癌、胆管癌、肺癌等,MSLN呈现高表达。MSLN在癌症细胞内的定位有较大差异,并与患者的生存期和预后有关。在多数癌症中,MSLN均一地分布于细胞表面,少量分布于细胞浆内。其异常表达通过促进癌细胞黏附、增殖、局部侵袭和转移,以及抵抗细胞毒剂诱导的凋亡,在肿瘤的恶性转化、侵袭性、化疗耐药方面发挥作用。
4. 癌胚抗原细胞粘附分子1(CEACAM1)
癌胚抗原细胞粘附分子(CEACAMs)是一类细胞表面糖蛋白家族,存在于上皮组织、内皮细胞和血细胞中,在非小细胞肺癌、黑色素瘤、结直肠癌和胰腺癌等多种恶性肿瘤中扮演着重要角色。CEACAM1与细胞黏附、细胞增殖、血管生成等细胞进程相关,能调控机体对肿瘤的免疫杀伤能力,参与肿瘤的免疫逃逸。同时,CEACAM1的高表达与多种肿瘤的不良预后相关。
5. MUC4
MUC4是一种含独特表皮生长因子样结构域的跨膜糖蛋白,兼具膜结合型蛋白和分泌型蛋白的特点,表达的糖蛋白位于黏膜上皮细胞膜的表面顶部。正常情况下能促进上皮细胞的更新和分化,对上皮组织有润滑和保护作用。MUC4可在正常上皮细胞中表达,包括消化道上皮黏膜,唾液腺和泪腺的导管上皮,喉和气管,肺,胃,肠,子宫,子宫颈,乳腺,卵巢和肾脏等。MUC4异常表达于许多肿瘤,包括胃癌、卵巢癌、肺癌、子宫内膜癌、胰腺癌和乳腺癌等。MUC4的过度表达与肿瘤的转移及抗凋亡相关,并参与关键的致癌信号通路,促进胰腺癌的侵袭性和化疗耐药性。
验证数据

胰腺癌标志物即用型IHC KIT产品
| 胰腺癌 | ||
| 靶标 | 货号 | 交叉反应 |
| S100P | IHC0165H | Human |
| MUC1 | IHC0166H | Human |
| MSLN | IHC0167H | Human |
| CEACAM1 | IHC0168H | Human |
| TYMS | IHC0169H | Human |
| MUC-4 | IHC0170H | Human |
| ERCC1 | IHC0171 | Human, Mouse |
| IHC0171H | Human | |
| IHC0171M | Mouse | |
| TOP2A | IHC0292 | Human, Mouse, Rat |
| IHC0292H | Human | |
| IHC0292M | Mouse | |
| IHC0292R | Rat | |
其他癌症标志物即用型IHC KIT产品
| 癌症名称 | 靶标 | 货号 | 交叉反应 |
| 肺癌 | GSTP1 | IHC0144H | Human |
| Ki-67 | IHC0246 | Human, Mouse, Rat | |
| MCM7 | IHC0145H | Human | |
| Napsin A | IHC0287 | Human, Mouse, Rat | |
| PD1/CD279 | IHC0288H | Human | |
| SOX2 | IHC0210 | Human, Mouse, Rat | |
| 乳腺癌 | ESR1 | IHC0146H | Human |
| PGR | IHC0147H | Human | |
| CK7 | IHC0148H | Human | |
| Caveolin-1 | IHC0149H | Human | |
| GATA3 | IHC0150H | Human | |
| KRT5 | IHC0162 | Human, Mouse | |
| SMMHC | IHC0151H | Human | |
| CADH1 | IHC0152H | Human | |
| Alpha Smooth Muscle Actin | IHC0114 | Human, Mouse, Rat | |
| KRT14 | IHC0153 | Human, Mouse, Rat | |
| 结直肠癌 | CALB2 | IHC0154 | Human, Mouse, Rat |
| MUC2 | IHC0155H | Human | |
| GPA33 | IHC0156H | Human | |
| Beta catenin | IHC0289 | Human, Rat | |
| Villin | IHC0157 | Human, Mouse, Rat | |
| CK20 | IHC0158H | Human | |
| CNN1/Calponin | IHC0290 | Human, Mouse, Rat | |
| 前列腺癌 | PSA | IHC0159H | Human |
| FOLH1 | IHC0160H | Human | |
| ACP3 | IHC0161H | Human | |
| VEGFA | IHC0291 | Human, Mouse, Rat | |
| 卵巢癌 | P53 | IHC0163H | Human |
| Pan CK | IHC0164 | Human, Mouse, Rat | |
| Vimentin | IHC0113H | Human | |
| 肾癌 | CD10 | IHC0172H | Human |
| CD34 | IHC0293 | Human, Mouse, Rat | |
| CD20 | IHC0125 | Human, Mouse, Rat | |
| 脑 | SYP | IHC0173 | Human, Mouse, Rat |
| 皮肤及软组织 | NCAM1 | IHC0174H | Human |
| Aging | Tau-4 | IHC0175 | Human, Mouse, Rat |
| AQP4 | IHC0295 | Human, Mouse, Rat | |
| TARDBP | IHC0177 | Human, Mouse, Rat | |
| SOD1 | IHC0178 | Human, Mouse | |
| SQSTM1/p62 | IHC0294H | Human | |
| SNCA | IHC0176 | Human, Mouse, Rat |